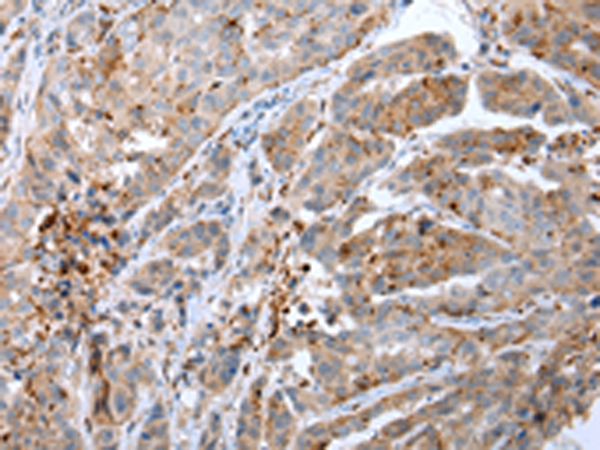

-
分类: 科研抗体货号: P12475别名: ECL; SLC; CKb9; TCA4; 6Ckine; SCYA21应用: WB反应种属: Human
-
分类: 科研抗体货号: P12476别名: FIC; MARC; MCP3; NC28; MCP-3; SCYA6; SCYA7应用: IHC反应种属: Human
-
分类: 科研抗体货号: P12492别名: CR; CAL2; CAB29应用: WB,IHC反应种属: Human, Mouse, Rat
-
分类: 科研抗体货号: P12474别名:应用: WB,IHC反应种属: Human, Mouse, Rat
-
分类: 科研抗体货号: P12491别名: BARS应用: WB,IHC反应种属: Human, Mouse, Rat
-
分类: 科研抗体货号: P12503别名: CATL1; CPT1P; CPTIC; SPG73; CPT1-B; CPTI-B应用: IHC反应种属: Human, Mouse, Rat
-
分类: 科研抗体货号: P12490别名: CLP1; NSR2; SRCL; SCARA4应用: WB,IHC反应种属: Human, Mouse, Rat
-
分类: 科研抗体货号: P12502别名:应用: WB,IHC反应种属: Human
-
分类: 科研抗体货号: P12488别名: FB22; HM89; LAP3; LCR1; NPYR; WHIM; CD184; LAP-3; LESTR; NPY3R; NPYRL; WHIMS; HSY3RR; NPYY3R; D2S201E应用: IHC反应种属: Human, Mouse, Rat
-
分类: 科研抗体货号: P12501别名: SFTA5; SFTPJ应用: WB,IHC反应种属: Human

鄂公网安备42018502007531号
鄂公网安备42018502007531号

